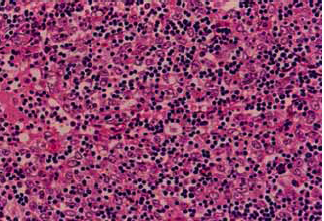
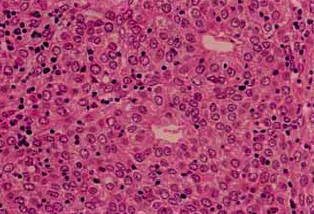

Thymoma and Thymic Cancers
Background
Thymomas comprise about 20% of all mediastinal tumors and 50% of all anterior mediastinal tumors. They arise from the thymus gland which is a derivation of the 3rd pharyngial pouch, embryologically. The thymus is associated with processing and maturation of T-cells to distinguish self from "non-self" antigens.
The mediastinum is subdivided into three sections: anterior, middle and posterior. The contents of these sections are:
- Anterior mediastinum: lymph nodes, mesenchymal tissues
- Middle mediastinum: Heart, Great vessels, trachea, esophagus, most mediastinal lymph nodes, vagus and phrenic nerves,
- Posterior mediastinum: paraspinal tissues, sympathetic and peripheral nerves
![]() |
About 1/3 of all mediastinal tumors are malignant. Thymomas account for 20% of all mediastinal tumors and 50% of all anterior mediastinal tumors. The median age at presentation is 40 - 60 years. The thymus is most active in the young, but most tumors do not arise until later in life. Thymomas are extremely rare in children.
Thymic carcinomas are much less prevelant than thymomas (< 1% of thymic tumors). These tumors are very aggressive and have poorer survival (OS-5 30% - 50%).
Pathology
The key distinguishing feature of thymoma is the coexistence of non-neoplastic lymphoid cells with neoplastic epitheliod cells.
WHO type is based on shape and on lymphocyte:epithelial ratio.
- WHO Type A-AB: benign thymoma, medullary, spindle cell
- WHO Type B1-B3: malignant thymoma, lymphocitic, cortical, epithelial, polygonal cells
- WHO Type C: Highly malignant, thymic carcinoma, clear cell/sarcomatoid types.
| B2 Thymoma | B3 Thymoma |
|---|---|
![]() |
![]() |
Lymph node metastatic rates are related to WHO grade. Thymomas rarely (1% - 2%) metastasize to the nodes, but thmic carcinomas metastasized about 30% of the time. Hematologic disseminatin is likelwise uncommon in thymomas at about 1%, mostly to lung Thymic carcinomas metastasize more more frequently at 12% to lung then bone, then liver.
Workup and Staging
Mediastinal mass diagnoses are divided by section.
- Anterior Mediastinum: thymoma, thymic carcinoma, carcinoid, germ cell tumors, lymphomas (Thymoma, Teratoma, Terrible lymphoma)
- Middle Mediastinum: cysts > lymphomas, teratomas > sarcomas (osteosarcoma, fibrosarcoma, angiosarcoma, rhabdomyosarcoma of the heart)
- Posterior: neurogenic tumors (PNET, schwannoma, neurofibroma, neuroblastoma, ganglioneuroma), pheochromocytoma
Most mediastinal tumors are diagnosed incidently from imaging studies due to cough. Symptoms are:
- cough
- stridor
- pain
- shortness of breath
- Horner Syndrome
- SVC syndrome
- Hypertension secondary to catacholamines
- myasthenia gravis (in thymomas approximately 35% - 50% present with myasthenia gravis and 10% - 15% of myasthenia gravis patients have thymomas.)
Most thymomas or thymic carcinomas present as incidental findings. If there are symptoms, they demonstrate locally advanced disease, metastatic symptoms, or paraneoplastic disorders. Paraneoplastic disorders are seen in 50% - 60% of thymomas but not generally seen in thymic carcinomas.
Paraneoplastic Syndromes seen in thymomas
Myasthenia gravis is seen in 30% 50% of thymomas. red cell aplasia is seen in 5% and immune deficiency syndromes are seen in 5%. Autoimmune disorders are also seen (collagen vascular, dermatologic, endcrine and renal disease.) and other malignancies such as lymphomas, GI and breast cancers, and Kaposi sarcomas.
Myasthenia gravis is an autoantibody to acetylcholine receptors at the post synaptic endplate in motor neurons. It presents with easy muscle fatigability and partial ptosis and diplopia which worsens with movement. Myasthenia gravis is diagnosed by Tensilon (edrophonium) test, and is treated by anti-acetylcholineesterase agents such as pyrodostigmine or thymectomy.
Mediastinal mass workup consists of
- (all together now, in unison): "H&P!"; ask about B signs of fever > 38, drenching night sweats, weight loss > 10% in the last six months. PE to assess nodal status, myasthenia gravis symptoms.
- labs: LDH, ESR, CBC, AFP/βHCG (germ cell tumors)
- Imaging: CXR, CT chest, MRI, PET (if lymphoma suspected)
- Biopsy: Core needle biopsy preferred or VATS but if necessary, FNA. CNB or excisional biopsy preserves architecture in lymphomas.
- PFTs to assess lung function.
- Presentation of any mediastinal mass with symptoms of myasthenia gravis, red cell aplasia, or hypogammaglobinemia is pathognomonic for thymoma.
Staging
The Masaoka Staging System is used.
| I | encapsulated with no microscopic capsular invasion |
| II | macroscopic invasion into surrounding fat or mediastinal pleura, or microscopic capsular involvement |
| III | extension to surrounding organs or great vessels |
| IVA | pleural or pericardial dissemination |
| IVB | + lymph nodes or distant mets. |
The Masaoka Staging system predicts OS-5 for thymomas:
- I: 95%
- II 90%
- III 60%
- IV 11% - 50%
The five year survival rate for invasive disease is 50% and for non-invasive disease it is 70%.
The two most important prognostic factors for thymoma are 1.) Masaoka Stage and 2.) completeness of resection.
Completeness of resection reported n modern surgical series on a Masaoka Stage By Stage Basis for 1,320 patients is given in the table below.
| Stage | % Complete Resection | % Recurrence | OS-5 |
|---|---|---|---|
| I | 100% | 1% | 100% |
| II | 100% | 4% | 98% |
| III | 85% | 28% | 89% |
| IVA | 42% | 34% | 71% |
For thymic carcinomas the most important prognostic indicators are different from thymomas. The most important prognostic indicators in thymic carcinomas are completeness of resection and lymph node status. OS-5 for thymic carcinomas is 20% - 30%.
Treatment and Outcomes
Surgery
Surgery is the most important treatment modality in the management of thymomas. Complete resection is the primary goal. The outcome is completely dependent upon the extent of resection and completeness of resection with OS-5 of 100% if the thymoma can be completely resected. The surgeon should mark problematic areas with surgical clips to identify difficult areas to resect or areas concerning for residual disease. Resection of pleural metastases should be considered since there is a possiblity of prolonged survival.
Signs and symptoms of myasthenia gravis should be medically controlled prior to surgery with acetylcholinesterase inhibitors to directly improve muscle function. These include pyridostigmine and neostigmine.
The usual surgical approach is a median sternotomy. More extensive resections may be required depending on presenting stage, including partial or total pneumonectomy or pericardectomy. Radiation therapy should be considered in all cases of Stage III/IVA disease, close or positive surgical margins and thymic carcinomas.
Post operative chemotherapy-radiation therapy should be considered for thymoma with residual disease and thymic cancer with R1/R2 resections per the NCCN 2011 recommendations.
Chemotherapy
Chemotherapy is used neoadjuvantly, prior to surgery or radiation therapy with typical response rates of 50% - 60% for induction chemotherapy in thymic malignancies.
For unresectable thymic tumors several management approaches are available:
- Radiation alone
- Induction chemotherapy → surgery → radiation
- Pre-operative radiation
Thymic malignancies
For unresectable thymic malignancies the treatment paradigms are:
- Chemotherapy → Radiation therapy (no surgery) (Loehrer 1997 JCO)
- Cisplatin/doxorubicin/cyclophosphamide (PAC) x 2 - 4 cycles induction chemotherapy
- → radiation to ≥ 54 Gy to primary + regional lymph nodes
- OS5 was 53%
- Chemotherapy → surgery if possible → PORT (MDACC: Shin, Ant. Int. Med. 1998)
- Induction chemotherapy x 3 cycles (CAP+prednisone)
- → maximum feasible surgery
- → Radiation therapy
- 7 year follow up demonstrated 100% OS and 73% DFS.
First line combination chemotherapy for thymic malignancies include:
- CAP (cytoxan/adriamycin/cisplatin) ± prednisone
- cisplatin/etoposide (EP)
- carboplatin/taxol
- cisplatin/adriamycin/vincristine/cytoxan (ADOC)
- cytoxan/adriamycin/vincristine/prednisone (CHOP)
Typical response rates with first line induction chemotherapies is 50% - 60%. The most common approach to thymic malignancies is maximum possible surgery → post-operative chemo-radiotherapy. If inoperable, consider induction chemotherapy, radiation therapy or combination chemo-radiation therapy.
Radiation Therapy
Definitive radiation therapy for unresectable thymic tumors as sole modality yields OS-5 of 50% - 87%. Surgery should be done whenever possible as degree of resection is the most important prognostic factor.
PORT
Adjuvant post-operative radiation therapy in State II thymoma is controversial. Masaoka Stage II thymoma is defined as macroscopic invasion into the surrounding fat or mediastinal pleura or microscopic capsular invasion. PORT was based on a review by Curran in 1988 (JCO) which examined 103 patients with thymomas. Curren reported patients without PORT had increased local recurrence (6/19 for Stage II without PORT and 0/1 Stage II 0/4 Stage III).
More recent data from MGH and Japan show that PORT may not be necessary in completely resected early thymomas. Hanuida (Japan) did demonstrate RT may be beneficial in thymoma with macroscopic adherence to the pleura did benefit from PORT with local recurrence of 0% with PORT compared with 36% without. They showed that PORT was not useful with microscopic invasion of the pleura or pericardium.
A Meta-analysis (Korst 2009 Ann.Thorac.Surg) between 1981 - 2008 of 13 studies covering 592 patients with 42% having surgery + PORT demonstrated no benefit to local recurrence for Stage II-III thymoma (OR 0.87 p=0.69).
A SEER database review from 1973 - 2005 of 901 patients (Forquer 2009 IJROBP), consisting of 92% thymoma and 8% thymic carcinoma with localized disease in 274 patients and regional disease in 626 patients reported that OS-5 improved with surgery + PORT for those with regional disease to 76% from 66%. For localized disease surgery alone was better.
- positive or close surgical margin
- Close margin is defined as ≤ 1 mm
- gross fibrous adhesions to the pleura
- Increased WHO Grade disease -- B3 (lymphoid infiltrate, polygonal cells
NCCN 3.2011 recommendations for post-operative Chemo-radiotherapy include thymoma with gross residual disease or thymic carcinoma with R1-R2 resection.
PORT: Post-operative Target Volumes and Doses
Radiation therapy post operative target volumes should inlclude the entire surgical bed and any adjacent involved organs. A pre-operative CT is essential to help define the tumor bed volumes, including op-notes and pathology reports identifying areas that had adherent lesions or invasion.
Post operative doses are:
- R0: 45 - 54 Gy
- R1: 55 - 60 Gy
- R2: 60 - 70 Gy
High risk subclinical sites in the surgical bed and at risk lymphatic regions should be covered. Unless indicated, the entire mediastinum and supraclavicular space does not need to be covered.,
Radiation for Unresectable Thymic Tumors
Radiation therapy can be used as sole modality treatments for unresectable thymic tumors. OS-5 is 50% - 87%. Surgery should be performed whenever feasible since resectability is a key prognostic indicators.
Pre-operative radiation therapy can also be considered with concurrent chemotherapy. If pre-operative RT is to be used, 24 - 30 Gy with chemotherapy → surgery → additional radiation consideration depending on resection status.
Toxicity and Late Effects
Follow up:
Completely resected thymoma patients should have an annual H&P and an annual Chest CT. Late recurrences beyond 5 years have been reported beyond 10 years. Life long follow-up is the rule.
Toxicity
Early radiation toxicities are: skin, fatigue, dysphagia, odynophagia, cough
Late radiation toxicities are: pneumonitis/fibrosis, pericarditis, esophageal stricture, myelitis.
Dose Limiting Structures and Volumes of the Mediastinum
Lung (RT alone):V20 < 40 Gy
Lung (Ch/RT): V20 < 35%. (MDACC: keep V5 < 40%, V20 < 30%, V30 < 8%)
Heart (RT alone): V40 < 50%
Heart (Ch/RT): V40 < 40%
Spinal Cord: ≤ 45 Gy
Esophagus:
- mean dose < 34 Gy
- Minimize V60 as much as practical
- V60 < 33%
- V50 < 50%
- ≤ 45 Gy to the entire esophagus
- < 70 Gy maximum dose point